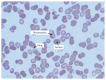

Babesia microti acquired in Canada
- PMID: 34373269
- PMCID: PMC8367421
- DOI: 10.1503/cmaj.201983
Babesia microti acquired in Canada
Conflict of interest statement
Competing interests: None declared.
Figures

References
-
- Krause PJ. Human babesiosis. Int J Parasitol 2019;49:165–74. - PubMed
-
- O’Brien SF, Delage G, Scalia V, et al. . Seroprevalence of Babesia microti infection in Canadian blood donors. Transfusion 2016;56:237–43. - PubMed
-
- Tonnetti L, O’Brien SF, Gregoire Y, et al. . Prevalence of Babesia in Canadian blood donors: June-October 2018. Transfusion 2019;59:3171–6. - PubMed
Publication types
MeSH terms
Substances
LinkOut - more resources
Full Text Sources